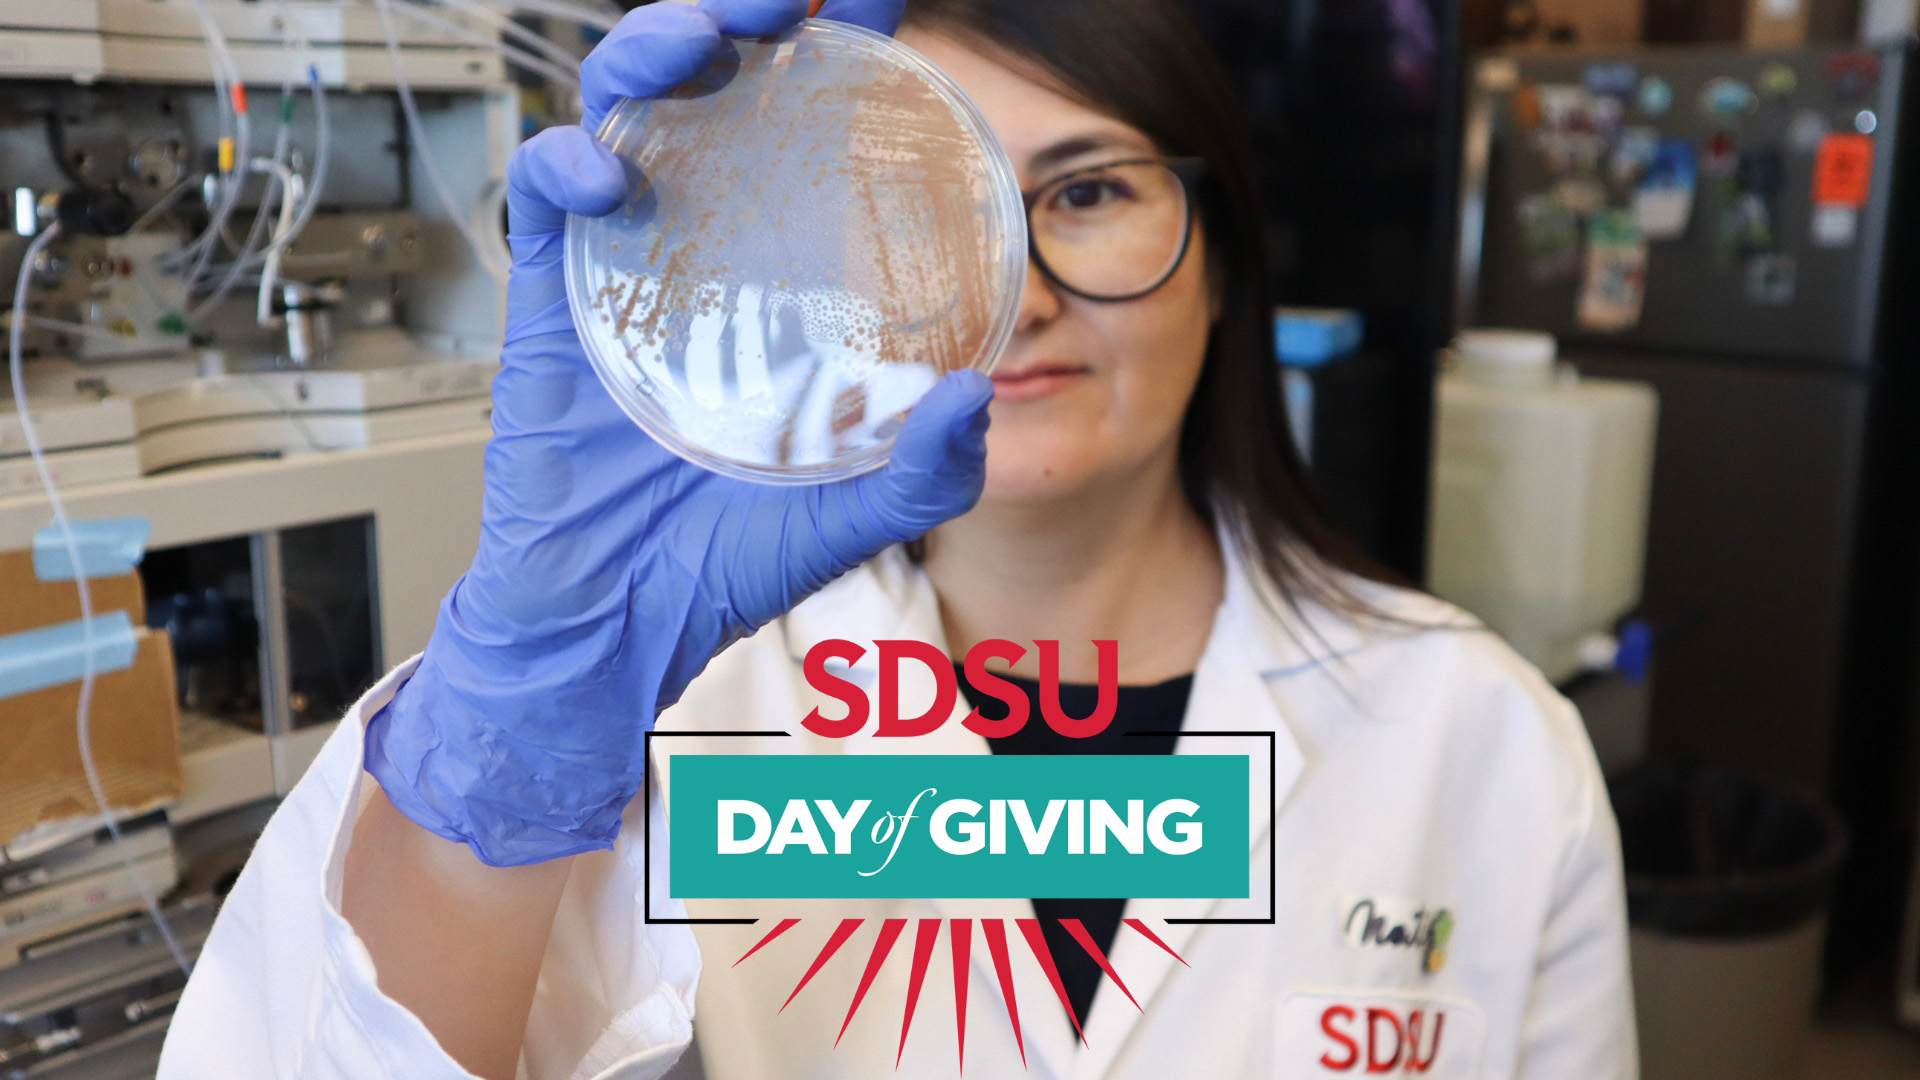

News
Celebrating with Science
Sep 25Emeritus Professor of Biology Jim Neel and hydrogeology alumna Helen Corley returned to SDSU for birthday festivities.
College of Sciences New Faculty 2025-26
Aug 26The College of Sciences celebrates the arrival of new faculty members whose expertise and dedication will enhance learning, foster discovery, and inspire the next generation of scientists
Eight SDSU students earn prestigious CSU pre-doctoral scholarships
Aug 26Selected for the 2025-26 California Pre-Doctoral Program, students will receive funding and mentorship to pursue doctoral studies and diversify the future professoriate.
A Global Enterprise
May 2SDSU sciences professors have worldwide impact with research projects around the globe
Aztecs in Research: Carlo Quintanilla Advocates for Science Policies at the NIH
Apr 30This Sciences alum got his start studying how stem cells can help regenerate the nervous system as an undergrad at SDSU
Science is in Bloom This Semester!
Apr 18Our students conduct research with real impact. And this spring, they got to show it off at events like the SDSU Student Symposium, (S3) and the Sustainability Summit!
Don’t Lose Your Head Over It!
Apr 9Undergraduate chemistry student Yesenia Rodriguez Reyes tackles a biological mystery when nematodes turn up without their heads — and bacteria become the prime suspect.
2025 Thomas B. Day Award for Excellence in Physics
Apr 9Congratulations to the recipients of the 2025 Thomas B. Day Award for Excellence in Physics!
Day of Giving 2025
Mar 12SDSU is an important center of knowledge creation for our region and state, and the College of Sciences is integral to this mission
First Semester Reflections From a Sciences Transfer Student
Jan 1Born in the U.S., Jia Gapuz grew up in the Philippines and returned to the States three years ago.